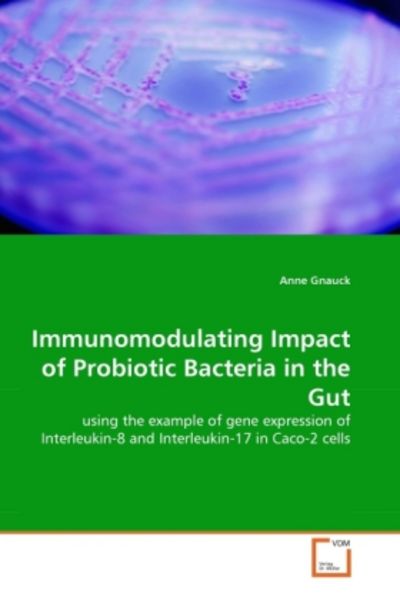

Ergebnisse für "probiotics"

cdVet VeaVet Probiotic-Spray, 100ml
€14.95(€149,500.00 / l)
inkl. MwSt. zzgl. Versand
Versand: €5.50

BE + RADIANCE COLOR+GLOW Probiotic Blush+Highlighter - N°03
€29.00(€2,900.00 / kg)
inkl. MwSt. zzgl. Versand

Probiotic Research in Therapeutics
€155.17
inkl. MwSt. zzgl. Versand
Versand: €0.00
Garden of Life Raw Probiotics Ultimate Care, 30 Kapseln
€46.51(€1,550,333.33 / kg)
inkl. MwSt. zzgl. Versand
Versand: €4.90

Isolation And Identification Of Probiotics On Shrimp (Buch)
€61.33
inkl. MwSt. zzgl. Versand
Versand: €0.00

Declaré Probiotic Skin SolutionGesicht | 50.0 ml | 1112,00 / 1.0 l
€55.60(€1,112.00 / l)
inkl. MwSt. zzgl. Versand
Versand: €0.00

Venn Probiotic-Tensive Hydro Firming Body Cream 200 ml
€116.44(€582.20 / l)
inkl. MwSt. zzgl. Versand
Versand: €0.00

Gynofit Probiotic Neo
€24.99(€2,776,666.67 / kg)
inkl. MwSt. zzgl. Versand
Versand: €4.95

Probiotics
€55.83
inkl. MwSt. zzgl. Versand
Versand: €0.00

SANTAVERDE Aloe Vera - Probiotic Drops
€34.90(€1,163.33 / l)
inkl. MwSt. zzgl. Versand

Now Foods Probiotic-10 25 Billion, 100 Kapseln
€39.43(€788,600.00 / kg)
inkl. MwSt. zzgl. Versand
Versand: €4.90

Probiotics in Agroecosystem
€146.91
inkl. MwSt. zzgl. Versand
Versand: €0.00

Garden of Life Dr. Formulated Probiotics Organic Kids+, 30 Kautabletten, Berry Cherry
€22.53(€450,600.00 / kg)
inkl. MwSt. zzgl. Versand
Versand: €4.90

AllNutrition | Probiotic Easy Digest | Lab2Pro Series
€47.95
inkl. MwSt. zzgl. Versand
Versand: €0.00

BE + RADIANCE SET+GLOW Probiotic Powder+Highlighter - N°70
€29.00(€2,900.00 / kg)
inkl. MwSt. zzgl. Versand

Enzymedica Digest Basic + Probiotics, 30 Kapseln
€10.80(€540,000.00 / kg)
inkl. MwSt. zzgl. Versand
Versand: €4.90

Sera Koifutter Professional Probiotic 500 g
€12.99(€25,980.00 / kg)
inkl. MwSt. zzgl. Versand
Versand: €5.49

Natures Plus GI Natural ProBiotic Men – 30 Kapseln
€45.90
inkl. MwSt. zzgl. Versand
Versand: €4.50

Probiotics as Live Biotherapeutics for Veterinary and Human Health,...
€170.67
inkl. MwSt. zzgl. Versand
Versand: €0.00

BE + RADIANCE SET+GLOW Probiotic Powder+Highlighter - N°30
€29.00(€2,900.00 / kg)
inkl. MwSt. zzgl. Versand

Nahrungsergänzungsmittel Duolife Probiotic Prebiotic Postbiotic Kapseln 40 Stück Probactilardii
€50.39
inkl. MwSt. zzgl. Versand
Versand: €0.00

Declaré Probiotic Skin Solution Firming Anti-Wrinkle Concentrate | Parfümerie Godel
€72.95(€1,459,000.00 / l)
inkl. MwSt. zzgl. Versand
Versand: €0.00

2x KETO PROBIOTIX PROBIOTIC - Nahrungsergänzungsmittel 120g
€64.75
inkl. MwSt. zzgl. Versand
Versand: €5.00

Prebiotics and Probiotics
€107.99
inkl. MwSt. zzgl. Versand
Versand: €0.00

Declaré Probiotic Skin Solution Firming Anti-Wrinkle Concentrate 50 ml Spender - Parfümerie Becker
€72.00(€1,440.00 / l)
inkl. MwSt. zzgl. Versand

BIOGAIA PROTECTIS BABY Tropfen Probiotic Probiotisch 5ML Probiotika für Säugling, MiL4 UNTERSETZER
€17.99
inkl. MwSt. zzgl. Versand
Versand: €2.90

SET+GLOW Probiotic Powder+Highlighter - N°33 10g
€31.90
inkl. MwSt. zzgl. Versand
Versand: €4.90

SET+GLOW Probiotic Powder+Highlighter - N°13 10g
€31.90
inkl. MwSt. zzgl. Versand
Versand: €4.90

Handbook of Prebiotics and Probiotics Ingredients
€328.86
inkl. MwSt. zzgl. Versand
Versand: €0.00

Probiotic Research in Therapeutics
€164.70
inkl. MwSt. zzgl. Versand
Versand: €0.00

Optibac Probiotics Every Day – 90 Kapseln
€10.87
inkl. MwSt. zzgl. Versand
Versand: €0.00

PRO VIT. D+ PROBIOTICS crema activadora 50ml
€24.96
inkl. MwSt. zzgl. Versand
Versand: €0.00
Doctors Best Digestive Health Probiotic 2 Billion with LactoSpore, 60 Kapseln
€18.90(€315,000.00 / kg)
inkl. MwSt. zzgl. Versand
Versand: €4.90

Probiotic in Animals
€107.86
inkl. MwSt. zzgl. Versand
Versand: €0.00

GYNEBAL CALM Probiotics Befeuchtungsgel Damen Scheidentrockenheit Vaginal Juckreiz
€37.99
inkl. MwSt. zzgl. Versand
Versand: €0.00

Monteil ProBeActive Probiotic Activating Fluid 50 ml
€37.95(€759.00 / l)
inkl. MwSt. zzgl. Versand
Versand: €0.00

BE + RADIANCE SET+GLOW Probiotic Powder+Highlighter - N°50
€29.00(€2,900.00 / kg)
inkl. MwSt. zzgl. Versand

Dr. Rimpler SPECIAL Mask Probiotic Skin Food 75 ml
€37.95(€506.00 / ml)
inkl. MwSt. zzgl. Versand

Image Skincare I MASK Purifying Probiotic Mask 57 g
€59.00(€1,035.09 / kg)
inkl. MwSt. zzgl. Versand
Versand: €0.00

60x 1g Fortiflora Feline Probiotic PRO PLAN Ergänzungsfutter für Katzen
€63.49(€1,058,166.67 / kg)
inkl. MwSt. zzgl. Versand
Versand: €0.00

FAQ Swiss Scalp Recovery & Thick Hair Probiotic Serum 60 ml
€74.90(€1,248.33 / l)
inkl. MwSt. zzgl. Versand
Versand: €0.00

Probiotic drops Serum 30 ml
€22.66(€755,333.33 / l)
inkl. MwSt. zzgl. Versand
Versand: €3.99

-Kult Boosted Extra Strength Probiotics 15 Capsules 1 Unit
€24.18
inkl. MwSt. zzgl. Versand
Versand: €6.10

Probiotic Research in Therapeutics
€98.83
inkl. MwSt. zzgl. Versand
Versand: €0.00

cdVet VeaVet Probiotic-Spray, 50ml
€10.95(€219,000.00 / l)
inkl. MwSt. zzgl. Versand
Versand: €5.50

Lactovit Activit Probiotic-L 0 Desodorante Spray 200ml
€7.75
inkl. MwSt. zzgl. Versand
Versand: €4.00

-Kult Protexin Infantis Probiotics For Children With 7 Strains Of Live Friendly Bacteria - 16 Sachets
€19.16
inkl. MwSt. zzgl. Versand
Versand: €6.10

Nourished by Time: Nourished By Time: Erotic Probiotic 2 - - (LP / E)
€37.61
inkl. MwSt. zzgl. Versand
Versand: €0.00

BINELLA dermaGetic Probiotic Skin Shield 2 x 30 ml
€101.70(€1,695.00 / ml)
inkl. MwSt. zzgl. Versand

Assessment of Effect of Probiotics on Salivary Streptococcus Mutans: Assessment of Effect of Probiot - LAP Lambert Acade...
CHF 35.54
inkl. MwSt. zzgl. Versand

Vichy Mineral 89 Probiotic Fractions Regenerierender & Reparierender Booster Feuchtigkeitsserum 30 ml
€40.09(€1,336.33 / l)
inkl. MwSt. zzgl. Versand
Versand: €0.00

Sensas Probiotic ProBio Boilie Monster Crab Durchmesser 14mm
€30.99
inkl. MwSt. zzgl. Versand
Versand: €6.99

Garnier Skin Active 2 Million Probiotics ReparierendeGesicht | 22.0 g | 72,27 / 1.0 kg
€1.59(€72.27 / kg)
inkl. MwSt. zzgl. Versand
Versand: €4.95

BE + RADIANCE SET+GLOW Probiotic Powder+Highlighter - N°40
€29.00(€2,900.00 / kg)
inkl. MwSt. zzgl. Versand

Probiotics and Child Gastrointestinal Health
€240.94
inkl. MwSt. zzgl. Versand
Versand: €0.00

3x Beauty of Joseon Rice Probiotics Sunscreen Spf 50+ Sunscreen
€46.99
inkl. MwSt. zzgl. Versand
Versand: €0.00

Santaverde Probiotic Drops ohne Duft 30 ml Damen
€39.43(€1,314.33 / l)
inkl. MwSt. zzgl. Versand
Versand: €0.00

Declaré Probiotic Skin Solution Multi Regeneration Cream Anti-Aging Pflege Damen 50 ml
€49.43(€988.60 / l)
inkl. MwSt. zzgl. Versand
Versand: €0.00

Now Foods Clinical GI Probiotic, 60 Kapseln
€20.90(€418,000.00 / kg)
inkl. MwSt. zzgl. Versand
Versand: €4.90

Beauty of Joseon Relief Sun: Rice + Probiotics SPF 50+ Sonnencreme 50 ml
€12.39(€247.80 / l)
inkl. MwSt. zzgl. Versand
Versand: €4.95

Garnier Skin Naturals Regenerating Sheet Mask with Probiotics 22g
€5.33
inkl. MwSt. zzgl. Versand
Versand: €3.99

Probiotics 3
€145.79
inkl. MwSt. zzgl. Versand
Versand: €0.00

Probiotics and Child Gastrointestinal Health
€212.66
inkl. MwSt. zzgl. Versand
Versand: €0.00

Vichy Mineral 89 Probiotic Fractions Konzentrat 30 ml
€29.91(€997,000.00 / l)
inkl. MwSt. zzgl. Versand
Versand: €3.99

N°1 Probiotic Intestinalen Unterstützung Flachen Bauch
€44.00
inkl. MwSt. zzgl. Versand
Versand: €0.00
Nordic Naturals Nordic Flora Probiotic Daily, 60 Kapseln
€25.95(€432,500.00 / kg)
inkl. MwSt. zzgl. Versand
Versand: €4.90

Gynofit Probiotic Neo Kapseln 30 St
€18.27(€1,602,631.58 / kg)
inkl. MwSt. zzgl. Versand
Versand: €3.99

Lab One N1 ProBiotic, 10 kapsułek
€22.02
inkl. MwSt. zzgl. Versand
Versand: €0.00

Beauty of Joseon Relief Sun: Rice + Probiotics SPF 50+Körper | 50.0 ml | 247,80 / 1.0 l
€12.39(€247.80 / l)
inkl. MwSt. zzgl. Versand
Versand: €4.95

Probiotics Gas & Bloating (120 Kapseln) Nahrungsergänzungsmittel, Probiotika, Verdauung, Magen, Darm, Verdauungsgesundheit, Blähungen, Darmgesund...
€49.99
inkl. MwSt. zzgl. Versand
Versand: €0.00

Sensas Probiotic ProBio Boilie Monster Crab Durchmesser 20mm
€38.99(€15,596.00 / kg)
inkl. MwSt. zzgl. Versand
Versand: €5.99

Gallinee, Microbiome Skincare, Prebiotics & Probiotics, Hydrating, Eye Cream, 15 ml
€19.19
inkl. MwSt. zzgl. Versand
Versand: €4.00

Natures Plus Ultra Probiotics- 60 Kapseln
€91.51
inkl. MwSt. zzgl. Versand
Versand: €0.00

Biossance Probiotic Gel Tagescreme 50 ml
€37.60(€752.00 / l)
inkl. MwSt. zzgl. Versand
Versand: €0.00

Colostrum + Probiotics Blend 5250mg (120 Kapseln) Nahrungsergänzungsmittel, Magen, Darm, Verdauung, Darmgesundheit, Immunsystem
€49.99
inkl. MwSt. zzgl. Versand
Versand: €0.00

Probiotic Research in Therapeutics
€164.58
inkl. MwSt. zzgl. Versand
Versand: €0.00

NaturVet Advanced Probiotics +70 Chews Ergänzungsfuttermittel für Hunde
€22.99(€117,295.92 / kg)
inkl. MwSt. zzgl. Versand
Versand: €2.99

KAPSELN ZUR UNTERSTÜTZUNG DER DARMFUNKTION (PROBIOTIC ME) 60 Stück (30 Stück x 2) – HEALTH LABS CARE
€51.41
inkl. MwSt. zzgl. Versand
Versand: €0.00

Probiotics as Live Biotherapeutics for Veterinary and Human Health, Volume 2
€207.29
inkl. MwSt. zzgl. Versand
Versand: €0.00

Now Foods Probiotic-10 50 Billion, 50 Kapseln
€33.78(€844,500.00 / kg)
inkl. MwSt. zzgl. Versand
Versand: €4.90

Gallinee, Body Care, Prebiotics & Probiotics & Postbiotics, Hydrating, Body Milk, 200 ml
€21.84
inkl. MwSt. zzgl. Versand
Versand: €4.00

Probiotics in Pediatric Medicine
€142.13
inkl. MwSt. zzgl. Versand
Versand: €0.00

Enzymedica Digest Gold + Probiotics, 90 Kapseln
€48.19(€688,428.57 / kg)
inkl. MwSt. zzgl. Versand
Versand: €4.90
Doctors Best Digestive Probiotic 20 Billion with Howaru, 30 Kapseln
€21.09(€1,054,500.00 / kg)
inkl. MwSt. zzgl. Versand
Versand: €4.90

PROBIOTICS ENERGY GLUTENFREIE PULVERMISCHUNG 140 g – PURASANA
€14.99
inkl. MwSt. zzgl. Versand
Versand: €5.73

sera Koi All Seasons probiotic 7 Kg
€83.99
inkl. MwSt. zzgl. Versand
Versand: €7.99

Probiotics - LAP Lambert Acade...
CHF 69.97
inkl. MwSt. zzgl. Versand

Hyeja VEGAN RICE PROBIOTICS GENTLE MICELLAR CLEANSING MILK 190 ml
€38.99(€205.21 / l)
inkl. MwSt. zzgl. Versand
Versand: €4.99

Sera Fischfutter Immune Probiotic Granules XS 1 L
€24.99
inkl. MwSt. zzgl. Versand
Versand: €5.49

Declaré Probiotic Multi Regeneration Cream 50 ml
€68.90(€1,378.00 / l)
inkl. MwSt. zzgl. Versand
Versand: €0.00

Biossance Feuchtigkeitspflege Squalane + Probiotic Gel Moisturizer Feuchtigkeitscreme Damen 50 ml
€35.25(€705.00 / l)
inkl. MwSt. zzgl. Versand
Versand: €0.00

The Good Gut Diet Cookbook: with Prebiotics and Probiotics
€18.33
inkl. MwSt. zzgl. Versand
Versand: €0.00

KORRES Probiotic Haut Supplement Nourishing Face Serum mit Priobiotika Griechischer Joghurt 30ml
€22.19
inkl. MwSt. zzgl. Versand
Versand: €6.10

NOW Foods Probiotic-10 & Bifido Boost, 90 caps
€19.42(€277,428.57 / kg)
inkl. MwSt. zzgl. Versand
Versand: €4.90

REACH Microbiome Toothpaste Total Care 120g Strong Mint Flavor Whitening Fresh Breath Anti-Plaque Probiotic Ingredients Clean Healthy Teeth Gums Ta...
€11.92
inkl. MwSt. zzgl. Versand
Versand: €0.00

Beauty of Joseon Rice Probiotics Sunscreen Spf 50+ Sunscreen
€23.99
inkl. MwSt. zzgl. Versand
Versand: €0.00

KORRES YOGHURT Probiotic Foaming Reinigungscreme 150 ml
€19.92(€132.80 / l)
inkl. MwSt. zzgl. Versand
Versand: €4.95

BE + RADIANCE SET+GLOW Probiotic Powder+Highlighter - N°13
€29.00(€2,900.00 / kg)
inkl. MwSt. zzgl. Versand

Korres Greek Yoghurt Probiotic Gel-Cream 40ml
€34.90(€872.50 / l)
inkl. MwSt. zzgl. Versand
Versand: €4.99
Gnauck, A: Immunomodulating Impact of Probiotic Bacteria in, Taschenbuch von Anne Gnauck, VDM, 9783639362060
€49.99
inkl. MwSt. zzgl. Versand
Versand: €0.00
